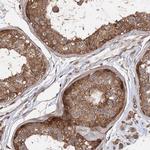
PACS1 Antibody in Immunohistochemistry (IHC)
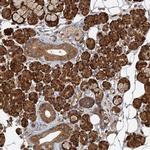
PACS1 Antibody in Immunohistochemistry (IHC)

Search
Invitrogen
PACS1 Polyclonal Antibody
{{$productOrderCtrl.translations['antibody.pdp.commerceCard.promotion.promotions']}}
{{$productOrderCtrl.translations['antibody.pdp.commerceCard.promotion.viewpromo']}}
{{$productOrderCtrl.translations['antibody.pdp.commerceCard.promotion.promocode']}}: {{promo.promoCode}} {{promo.promoTitle}} {{promo.promoDescription}}. {{$productOrderCtrl.translations['antibody.pdp.commerceCard.promotion.learnmore']}}
产品信息
PA5-58589
种属反应
已发表种属
宿主/亚型
分类
类型
抗原
偶联物
形式
浓度
规格
纯化类型
保存液
内含物
保存条件
运输条件
RRID
产品详细信息
Immunogen sequence: DTTSPMELAA LEKIKSTWIK NQDDSLTETD TLEITDQDMF GDASTSLVVP EKVKTPMKSS KTDLQGSASP SKVEGVHTPR QKRSTPLKER QLSKPLSE
Highest antigen sequence identity to the following orthologs: Mouse - 96%, Rat - 97%.
靶标信息
PACS-1 (CRA_a) is a 963 amino acid rich regulatory protein involved in protein trafficking and belongs to the PACS family. A coat protein involved in controlling the correct subcellular localization of trans-Golgi network (TGN) membrane proteins that contain acidic cluster sorting motifs, PACS-1 is also known to be involved in HIV-1 Nef-mediated removal of MHC-I from the cell surface to the TGN, thus enabling HIV-1 to escape immune surveillance. PACS-1 also controls the endosome to Golgi trafficking of furin and mannose-6-phosphate receptor by connecting the acidic-cluster-containing cytoplasmic domain of these molecules with the adapter-protein complex-1 (AP-1) of endosomal clathrin coated membrane pits. Usually seen in golgi apparatus, trans-Golgi network and localized in the paranuclear region, it is ubiquitously expressed in most of the tissues.
仅用于科研。不用于诊断过程。未经明确授权不得转售。
生物信息学
蛋白别名: cytosolic sorting protein PACS-1; PACS-1; Phosphofurin acidic cluster sorting protein 1; unnamed protein product
基因别名: KIAA1175; MRD17; PACS1; SHMS
UniProt ID: (Human) Q6VY07
Entrez Gene ID: (Human) 55690